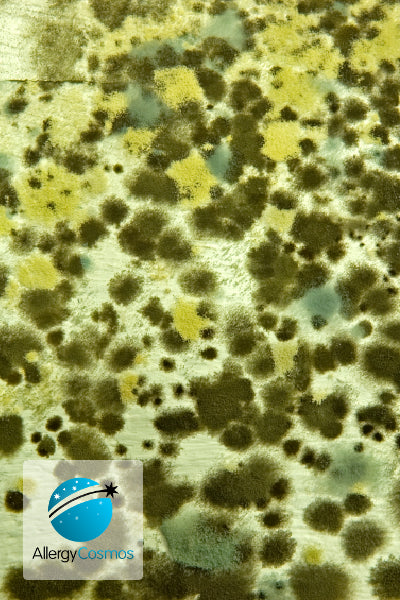

Mould Allergy
Mould spores are a potent allergen that can trigger severe asthma and rhinitis symptoms and cause a broad range of respiratory conditions. It occurs both indoors and outdoors and the density of mould spores is normally much higher than that of pollen. Your first step in keeping the mould count under control is to ensure that you tackle any damp areas. Another important step is to capture mould spores in the air, to prevent the mould from spreading.
Frequently Asked Questions
What is mould?
What is black mould?
What is Aspergillus?
What symptoms and health problems does mould cause?
Where does mould gather in the home?
What is the best way of preventing indoor mould?
How is mould removed?
How do I avoid mould outdoors?
Will an air purifier get rid of mould?
Related Products
-
IQAir HyperHEPA Filter
Regular price £179.00Regular priceUnit price per -
IQAir PreMax Filter F8
Regular price £89.00Regular priceUnit price per -
IQAir HealthPro 250 Filter: Replacement Set
Regular price £379.00Regular priceUnit price per -
IQAir GC MultiGas Cartridge-Filter
Regular price £329.00Regular priceUnit price per -
IQAir GC Post-Filter Sleeve Set
Regular price £109.00Regular priceUnit price per -
IQAir V5-Cell MG Filter
Regular price £119.00Regular priceUnit price per -
IQAir PreMax MG Filter
Regular price £119.00Regular priceUnit price per -
IQAir GC Series Pre-Filter
Regular price £109.00Regular priceUnit price per -
IQAir Atem HyperHEPA Filter
Regular price £75.00Regular priceUnit price per -
IQAir GC VOC Cartridge-Filter Set
Regular price £329.00Regular priceUnit price per -
IQAir GC Chemisorber Cartridge-Filter Set
Regular price £379.00Regular priceUnit price per -
IQAir Atem HyperHEPA Plus Filter
Regular price £85.00Regular priceUnit price per